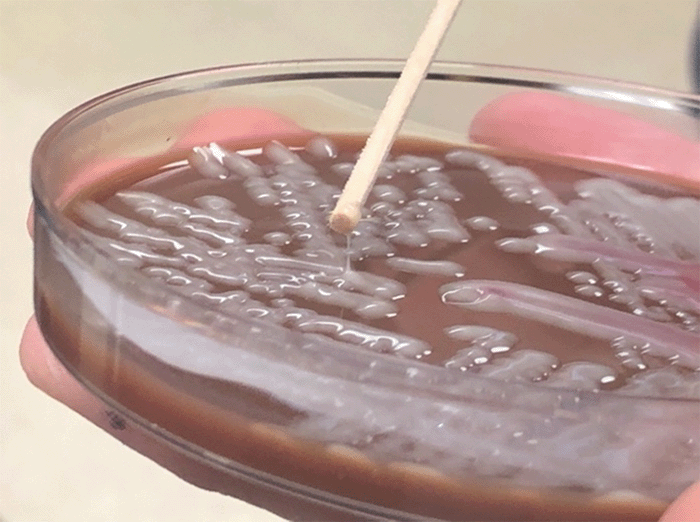

Laparoscopic-assisted Percutaneous Drainage of Hepatic Abscesses Caused by Hypermucoviscous Klebsiella pneumoniae
January 11, 2022
Abstract
Background
Hypermucoviscous Klebsiella pneumoniae is emerging as a serious infectious agent in North America. The hypermucoviscous strains of Klebsiella spp. are associated with increased virulence and morbidity. We describe the clinical presentation and surgical management of two patients with hepatic abscesses secondary to this subspecies of Klebsiella pneumoniae.
Summary
In the first case, a 25-year-old woman with Type II diabetes presented with fever, right upper quadrant abdominal pain, and vomiting. Abdominal and chest computed tomography revealed a large, irregular liver lesion consistent with a hepatic abscess and right lower lobe pneumonia. A hypermucoviscous strain of Klebsiella pneumoniae was isolated from sputum. The patient failed medical management but responded rapidly to laparoscopic-assisted drainage of the hepatic abscess. A 20-year-old man with Type I diabetes presented with fever, right upper quadrant abdominal pain, vomiting, and early satiety in the second case. Magnetic resonance imaging revealed a large, irregular liver lesion consistent with hepatic abscess. The patient required radiologic-guided placement of three percutaneous drains for ten days to accomplish resolution of the liver abscess.
Conclusion
Hypermucoviscous Klebsiella pneumoniae is an emerging infectious agent in the United States. We propose that laparoscopic-assisted placement of a surgical drain is an effective alternative to conventional radiologic-guided percutaneous drainage for hypermucoviscous Klebsiella pneumoniae hepatic abscesses due to the viscous nature of the abscess contents.
Keywords
hepatic abscess; Klebsiella pneumonia; hypermucoviscous strain; laparoscopy; surgery
Case Description
Infections due to hypermucoviscous Klebsiella pneumoniae (hvKp) were first described in the 1980s in Taiwan.1,2 Hepatic abscesses secondary to this strain (hvKp) are now being described in other Asian countries as well as in North America.2,3 These hepatic abscesses have been associated with diabetes mellitus2 with reported mortality as high as 10 percent.2,4–7
Klebsiella spp. are divided into several serotypes. K1 and K2 serotypes are both commonly isolated in patients with Klebsiella hepatic abscesses.2 These two serotypes are also associated with the hypermucoviscous phenotype, as defined by the string test. The string test evaluates the formation of a viscous "string" of greater than 0.5 cm in length elicited by stretching the colony material using an inoculation loop (Figure 1).2 Despite increasing reports of hvKP hepatic abscesses, the optimal treatment has not been well-established. Still, it often consists of parenteral antibiotics, effective drainage, and complete microbiologic characterization of the antibiotic sensitivities. The hypermucoviscosity of these collections appears to present a challenge to conventional techniques of drainage. We submit and compare the hospital course and outcomes for two patients diagnosed recently with hvKP hepatic abscesses.
Figure 1. Positive String Test From Case 1. Published with Permission
The string test evaluates formation of viscous "string" of greater than 0.5 cm in length elicited by stretching colony material using inoculation loop. A positive string test defines hypermucoviscous phenotype of Klebsiella pneumoniae.
In the first case, a 25-year-old woman with insulin-dependent, type II diabetes mellitus who had immigrated to the United States from Southeast Asia 12 years previously presented with fever, vomiting, and right upper quadrant (RUQ) abdominal pain. She had a white blood cell count of 14,900 cells/mm3, random blood glucose of 293 mg/dL, hemoglobin A1c of 12.5 percent, total bilirubin of 0.7 mg/dL, alkaline phosphatase of 112 units/L, aspartate aminotransferase (AST) of 232 units/L, and alanine aminotransferase (ALT) of 267 units/L (Table 1). A RUQ ultrasonography revealed a hepatic mass, and a subsequent abdominal and chest computed tomography (CT) delineated a large, irregular, hypodense, heterogeneous lesion in the right lobe of the liver, consolidation of the right lower lobe (RLL) of the lung, and diffuse lung ground-glass opacities, consistent with a hepatic abscess and an RLL pneumonia. Ultrasonographically-guided percutaneous drainage with a 5 French Yueh catheter was attempted; however, only 1 mL of viscous fluid could be aspirated. Due to initial concern for malignancy, a core needle biopsy was performed, which performed. These findings revealed no evidence of malignancy and instead were consistent with a hepatic abscess. Two days after admission, the patient began to clinically decompensate with increasing oxygen requirements, tachycardia up to 109 beats per minute, and blood pressure of 80/50 mmHg; blood cultures were drawn and demonstrated gram-negative bacteremia. The patient was then transferred to our intensive care unit (ICU) to manage septic shock, diabetic ketoacidosis, and acute hypoxic respiratory failure due to sepsis and RLL pneumonia. A hypermucoviscous strain of Klebsiella pneumoniae was isolated from the sputum. The patient failed to improve despite treatment with IV vancomycin and piperacillin/tazobactam. Repeat CT seven days later demonstrated enlargement of the hepatic abscess to 8.9 cm from 7.3 cm in the largest diameter (Figure 2A). After discussions among members of the infectious disease division, surgery, and interventional radiology, operative drainage was considered the optimal approach for this patient. The patient underwent laparoscopic-assisted, percutaneous, transperitoneal drainage of the abscess using a 26 French Malecot catheter placement into the abscess cavity, which drained approximately 40 mL of thick purulent material. A tongue of omentum was mobilized to wrap around the Malecot catheter to minimize leakage of purulent fluid into the abdominal cavity and avoid displacement of the catheter. Klebsiella pneumoniae was isolated from cultures obtained from the hepatic abscess and was found to have a positive string test (Figure 1). The patient clinically improved rapidly with gradual resolution of fever and leukocytosis. CT on postoperative day 7 demonstrated a 3 cm decrease in the size of the abscess (Figure 2B). The patient completed a six-week course of outpatient IV ceftriaxone. The Malecot catheter was removed seven weeks after placement.
Figure 2. Radiographic Images From Case 1. Published with Permission

A) Transverse section of CT chest/abdomen/pelvis from Case 1 obtained 9 days after admission and 2 days before surgery demonstrating 8.9 cm × 8.0 cm × 7.8 cm heterogenous, complex collection in right hepatic lobe; B) transverse section of CT chest/abdomen/pelvis from Case 1 obtained 7 days after surgery with contrast demonstrating slight decrease in size of right hepatic abscess, measuring 8.0 cm × 5.0 cm × 7.0 cm. Drainage catheter with intrahepatic tip is visualized
In the second case, a 20-year-old African-American man with type I diabetes mellitus and a history of recent travel to East Africa, presented with fever, vomiting, RUQ abdominal pain, and early satiety. The patient was febrile to 38.3°C, hypoxic, and demonstrated localized RUQ abdominal tenderness. Laboratory analysis revealed leukocytosis of 12,100 cells/mm3, a random blood glucose concentration of 340 mg/dL, total bilirubin of 1.3 mg/dL, alkaline phosphatase of 269 units/L, ALT of 50 units/L, AST of 98 units/L, and increased serum ketones (Table 1).
Table 1. Case 1 and Case 2 Details. Published with Permission
|
Case 1 |
Case 2 |
|
|
Initial Presentation |
||
|
Age |
25 |
20 |
|
Ethnicity |
Southeast Asian |
East African |
|
Presenting symptoms |
Fever, RUQ pain, nausea, vomiting |
Fever, early satiety, nausea, vomiting |
|
Comorbidity |
Type II Diabetes |
Type I Diabetes |
|
Concurrent diagnoses |
Acute hypoxic respiratory failure Diabetic ketoacidosis |
Acute hypoxic respiratory failure Acute appendicitis |
|
Physical exam findings |
Abdomen soft, nontender, distended |
RUQ tenderness to palpation |
|
WBC (/mm3) |
14,900 |
12,100 |
|
Glucose (mg/dL) |
293 |
340 |
|
Total Bilirubin (mg/dL) |
0.7 |
1.3 |
|
Alkaline phosphatase (U/L) |
112 |
269 |
|
AST (U/L) |
232 |
50 |
|
ALT (U/L) |
267 |
98 |
|
Hospital Course |
||
|
LOS (days) |
21 |
29 |
|
Time in ICU (days) |
6 |
7 |
|
Met SIRS Criteria1 (days) |
17 |
16 |
|
Radiologic interventions |
Unsuccessful radiologic-guided drain placement attempt x 1 |
Radiologic-guided drain placement x 3 |
|
Surgical interventions |
Laparoscopic placement of large hepatic drain |
None |
|
Antibiotics |
6-week course of outpatient IV antibiotics |
4-week course of outpatient IV antibiotics |
|
Case 1 |
Case 2 |
|
|
Initial Presentation |
||
|
Age |
25 |
20 |
|
Ethnicity |
Southeast Asian |
East African |
|
Presenting symptoms |
Fever, RUQ pain, nausea, vomiting |
Fever, early satiety, nausea, vomiting |
|
Comorbidity |
Type II Diabetes |
Type I Diabetes |
|
Concurrent diagnoses |
Acute hypoxic respiratory failure Diabetic ketoacidosis |
Acute hypoxic respiratory failure Acute appendicitis |
|
Physical exam findings |
Abdomen soft, nontender, distended |
RUQ tenderness to palpation |
|
WBC (/mm3) |
14,900 |
12,100 |
|
Glucose (mg/dL) |
293 |
340 |
|
Total Bilirubin (mg/dL) |
0.7 |
1.3 |
|
Alkaline phosphatase (U/L) |
112 |
269 |
|
AST (U/L) |
232 |
50 |
|
ALT (U/L) |
267 |
98 |
|
Hospital Course |
||
|
LOS (days) |
21 |
29 |
|
Time in ICU (days) |
6 |
7 |
|
Met SIRS Criteria1 (days) |
17 |
16 |
|
Radiologic interventions |
Unsuccessful radiologic-guided drain placement attempt x 1 |
Radiologic-guided drain placement x 3 |
|
Surgical interventions |
Laparoscopic placement of large hepatic drain |
None |
|
Antibiotics |
6-week course of outpatient IV antibiotics |
4-week course of outpatient IV antibiotics |
1SIRS criteria defined by ≥2 of the following criteria: heart rate >90, temperature >38°C or <36°C, respiratory rate >20, white blood cell count >12,000/mm3 or <4,000/mm3
RUQ, right upper quadrant
WBC, white blood cell count
AST, aspartate aminotransferase
ALT, alanine aminotransferase
LOS, length of stay
ICU, intensive care unit
SIRS, systemic inflammatory response syndrome
Magnetic resonance imaging (MRI) demonstrated an 8 × 8 × 7 cm irregular, heterogenous lesion in the right lobe of the liver suggestive of an intrahepatic abscess. A hypermucoviscous strain of Klebsiella pneumoniae was isolated from the blood. Despite antibiotic administration with ceftriaxone and metronidazole, the patient remained septic. A 14 French percutaneous drain was placed by radiologic guidance into a 7.6 cm gas-containing complex collection in the right hepatic lobe; however, the drain had minimal output. Repeat CT two days post-procedure confirmed appropriate drain placement but no decrease in the size of the intrahepatic abscess (Figure 3A). Klebsiella pneumoniae was isolated from cultures obtained from the hepatic abscess and was found to have a positive string test. The CT also revealed a perihepatic extension of the abscess, a pelvic fluid collection, and a dilated appendix associated with fat stranding, consistent with acute appendicitis, which was a possible source of the patient's liver abscess. On hospital day 12, the surgical team elected to manage the acute appendicitis nonoperatively and the abscess collections by the radiologic-guided placement of two additional 12 French percutaneous drains. The patient improved gradually over the next four days with resolution of fever and leukocytosis on hospital day 16. On hospital day 19, repeat CT demonstrated near-complete resolution of the intrahepatic abscess (Figure 3B). The right hepatic and pelvic drains were removed at discharge, and the perihepatic drain was and removed three weeks after discharge. The patient fully recovered after a four-week course of outpatient IV ceftriaxone.
Figure 3. Radiographic Images From Case 2. Published with Permission

A) Transverse section of CT chest/abdomen/pelvis obtained two days after radiologic-guided drain placement demonstrating 7.6 cm × 6.5 cm complex collection in right hepatic lobe with pigtail percutaneous drain along medial aspect of collection; B) transverse section of CT chest/abdomen/pelvis from obtained 26 days after initial drain placement, demonstrating near resolution of intrahepatic fluid collection
Discussion
Pyogenic hepatic abscesses caused by hvKP have been identified with increasing frequency in many reports from Asian countries.2 Recently, similar patient histories have been reported in Europe and North America.2,11 These hvKP hepatic abscesses are associated with high morbidity and mortality; in addition, other sites of hvKP infections have included septic endophthalmitis, meningitis, necrotizing fasciitis, septic pulmonary emboli, lung abscesses, and musculoskeletal abscesses.6,8,9
Pyogenic hepatic abscesses are often polymicrobial infections, which can be secondary to an intra-abdominal source and specifically infections originating from the biliary tree, appendicitis, or diverticulitis. In contrast, K. pneumoniae abscesses are most often primary, monomicrobial infections. The K1 and K2 serotypes, the most common strains isolated from K. pneumoniae hepatic abscesses, have been associated with resistance to phagocytosis and intracellular killing.2,5 The K1 serotype, although more commonly isolated, is less frequently associated with hypermucoviscous phenotype than is the K2 serotype.
Patients with Klebsiella hepatic abscesses may present a wide spectrum of clinical symptoms, including fever, chills, RUQ abdominal pain and tenderness, and vomiting.2 Pertinent laboratory findings may include abnormal liver function tests, mild to moderate leukocytosis, and mild thrombocytopenia.2 Positive blood cultures often contribute to the diagnosis. Although ultrasonographic examination avoids radiation exposure, the sensitivity for detecting hepatic abscesses is 86 percent compared to CT or MRI, which both have a sensitivity of around 97 percent.2,13,14 CT or ultrasound-guided percutaneous sampling/drainage can confirm the diagnosis, facilitate isolation and identification of the pathogen(s) using Gram stain and culture, and can be therapeutic.
A wide range of comorbidities has been associated with these abscesses, including diabetes, underlying hepatobiliary disease, malignancy, alcoholism, chronic renal failure, and cirrhosis, suggesting that predisposing factors are important in the susceptibility to this condition.2,15 Compared to non-Klebsiella hepatic abscesses, hvKP hepatic abscesses, due to their mucoid hyperviscous contents, are associated with the inability to aspirate the purulent material within the abscess cavity fully. This is especially true for small diameter percutaneously-placed drains and therefore may require prolonged drainage and extended antibiotic treatment course.16
Appropriate treatment of pyogenic hepatic abscesses requires the use of broad-spectrum antibiotics and effective drainage of the abscess. Several studies have suggested that operative drainage is more effective than percutaneous drainage for large, multiloculated abscesses and is associated with fewer treatment failures, a decreased number of secondary procedures to obtain adequate drainage and a decrease in the duration of hospital stay.18 In one case study, the patient with a hvKP hepatic abscess underwent placement of multiple percutaneous drains but ultimately required liver resection due to the inability to obtain adequate drainage and the resultant severity of the abscess.19 These reports suggest that while percutaneous drainage is a common approach, operative drainage done with the laparoscopic-assisted placement of a large-bore surgical drain may be most appropriate depending on the specific characteristics of the patient's clinical course and the hepatic abscess itself. Indeed, we suggest that for hvKP hepatic abscesses, laparoscopic-assisted placement of a surgical drain may be the ideal indication for this approach for several reasons. This approach allows the safe, direct visualization of catheter placement. This approach also provides the ability to "protect" the puncture site in the liver with an omental tongue secured around the drain to minimize intraperitoneal soilage from the abscess cavity. Using a large-bore surgical catheter will facilitate drainage of the mucoviscous material from the abscess cavity and permit a more rapid patient recovery. One can also irrigate the cavity via this catheter to accelerate intracavitary debridement to improve the drainage.
Conclusion
We describe the clinical presentation and management of two patients with Klebsiella pneumoniae hepatic abscesses. Hepatic abscesses with Klebsiella can be associated with mortality rates of 10 percent or higher, especially when associated with secondary extrahepatic infections or antibiotic resistance. The hepatic abscesses with the hvKP strain may be less amenable to percutaneous drainage and would benefit from a laparoscopic-assisted approach allowing a large-bore drainage catheter.
Lessons Learned
Optimal management of hepatic abscesses includes early diagnosis, effective drainage, and broad-spectrum antibiotics. We propose that laparoscopic-assisted placement of a surgical drain can be an effective first-line alternative to radiologic-guided percutaneous drainage.
References
- Liu YC, Cheng DL, Lin CL. Klebsiella pneumoniae liver abscess associated with septic endophthalmitis. Arch Intern Med. 1986;146(10):1913-1916.
- Siu LK, Yeh KM, Lin JC, Fung CP, Chang FY. Klebsiella pneumoniae liver abscess: a new invasive syndrome. Lancet Infect Dis. 2012;12(11):881-887. doi:10.1016/S1473-3099(12)70205-0
- Wang JH, Liu YC, Lee SS, et al. Primary liver abscess due to Klebsiella pneumoniae in Taiwan. Clin Infect Dis. 1998;26(6):1434-1438. doi:10.1086/516369
- Chiu CT, Lin DY, Liaw YF. Metastatic septic endophthalmitis in pyogenic liver abscess. J Clin Gastroenterol. 1988;10(5):524-527. doi:10.1097/00004836-198810000-00009
- Fung CP, Chang FY, Lee SC, et al. A global emerging disease of Klebsiella pneumoniae liver abscess: is serotype K1 an important factor for complicated endophthalmitis?. Gut. 2002;50(3):420-424. doi:10.1136/gut.50.3.420
- Cheng DL, Liu YC, Yen MY, Liu CY, Wang RS. Septic metastatic lesions of pyogenic liver abscess. Their association with Klebsiella pneumoniae bacteremia in diabetic patients. Arch Intern Med. 1991;151(8):1557-1559.
- Ko WC, Paterson DL, Sagnimeni AJ, et al. Community-acquired Klebsiella pneumoniae bacteremia: global differences in clinical patterns. Emerg Infect Dis. 2002;8(2):160-166. doi:10.3201/eid0802.010025
- Kudo M, Matono T, Morita M, et al. Molecular analysis of virulence factors of hypermucoviscous Klebsiella pneumoniae in a diabetes patient with multifocal intramuscular and musculoskeletal abscesses. J Infect Chemother. 2020;26(1):110-114. doi:10.1016/j.jiac.2019.06.001
- Chiu HHC, Francisco CN, Bruno R, Jorge Ii M, Salvaña EM. Hypermucoviscous capsular 1 (K1) serotype Klebsiella pneumoniae necrotising fasciitis and metastatic endophthalmitis. BMJ Case Rep. 2018;11(1):e226096. Published 2018 Nov 28. doi:10.1136/bcr-2018-226096
- Tang LM, Chen ST. Klebsiella pneumoniae meningitis: prognostic factors. Scand J Infect Dis. 1994;26(1):95-102. doi:10.3109/00365549409008596
- Lederman ER, Crum NF. Pyogenic liver abscess with a focus on Klebsiella pneumoniae as a primary pathogen: an emerging disease with unique clinical characteristics. Am J Gastroenterol. 2005;100(2):322-331. doi:10.1111/j.1572-0241.2005.40310.x
- Namikawa H, Yamada K, Sakiyama A, et al. Clinical characteristics of bacteremia caused by hypermucoviscous Klebsiella pneumoniae at a tertiary hospital. Diagn Microbiol Infect Dis. 2019;95(1):84-88. doi:10.1016/j.diagmicrobio.2019.04.008
- Lin AC, Yeh DY, Hsu YH, et al. Diagnosis of pyogenic liver abscess by abdominal ultrasonography in the emergency department. Emerg Med J. 2009;26(4):273-275. doi:10.1136/emj.2007.049254
- Park HJ, Kim SH, Jang KM, Lee SJ, Park MJ, Choi D. Differentiating hepatic abscess from malignant mimickers: value of diffusion-weighted imaging with an emphasis on the periphery of the lesion. J Magn Reson Imaging. 2013;38(6):1333-1341. doi:10.1002/jmri.24112
- Wang J, Yan Y, Xue X, Wang K, Shen D. Comparison of pyogenic liver abscesses caused by hypermucoviscous Klebsiella pneumoniae and non-Klebsiella pneumoniae pathogens in Beijing: a retrospective analysis. J Int Med Res. 2013;41(4):1088-1097. doi:10.1177/0300060513487645
- Hui JY, Yang MK, Cho DH, et al. Pyogenic liver abscesses caused by Klebsiella pneumoniae: US appearance and aspiration findings. Radiology. 2007;242(3):769-776. doi:10.1148/radiol.2423051344
- Baekby M, Hegedüs N, Sandahl TD, Krogfelt KA, Struve C. Hypervirulent Klebsiella pneumoniae K1 liver abscess and endogenous endophthalmitis in a Caucasian man. Clin Case Rep. 2018;6(8):1618-1623. Published 2018 Jul 3. doi:10.1002/ccr3.1696
- Tan YM, Chung AY, Chow PK, et al. An appraisal of surgical and percutaneous drainage for pyogenic liver abscesses larger than 5 cm. Ann Surg. 2005;241(3):485-490. doi:10.1097/01.sla.0000154265.14006.47
- Chan T, Lauscher J, Chan A, Law C, Karanicolas P. Hypermucoviscous Klebsiella pneumoniae liver abscess requiring liver resection. BMJ Case Rep. 2018;2018:bcr2018226490. Published 2018 Aug 20. doi:10.1136/bcr-2018-226490
Authors
Spartz EJa; Wheelwright Ma; Vakayil Va; Leuck A-Mb; Kalland Ka; Peter La; Michelson Da; Cohen Ma; Bulander Ra; Harmon JVa
Author Affiliations
- Department of Surgery, University of Minnesota Medical School, Minneapolis, MN 55414
- Department of Medicine, Division of Infectious Diseases and International Medicine, University of Minnesota Medical School, Minneapolis, MN 55414
Corresponding Author
Matthew Wheelwright, MD, PhD
Department of Surgery
University of Minnesota
420 Delaware Street SE, MMC 195
Minneapolis, MN 55455
Phone: (612) 715-1300
Email: wheel381@umn.edu
Disclosure Statement
The authors have no conflicts of interest to disclose.
Funding/Support
The authors have no relevant financial relationships or in-kind support to disclose.
Meeting Presentation
Surgical Infection Society 40th Annual Meeting, April 2020, Denver, CO (conference canceled)
Received: July 26, 2020
Revised received: October 12, 2020
Accepted for publication: November 1, 2020